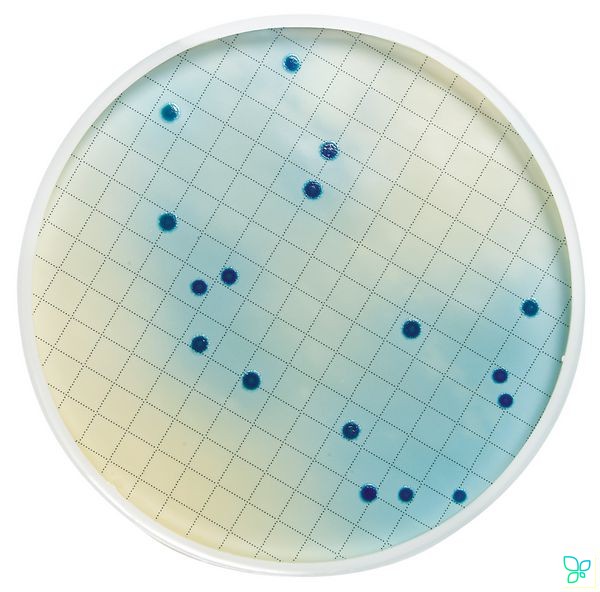

Микробиологические мониторы используются для анализа микробного загрязнения жидких образцов после их пропускания через фильтры. После фильтрации заданного объема жидкого образца фильтрующие мембраны пропитывают жидкими питательными средами общего или специального назначения. После инкубации в термостате проводят подсчет выросших на мембранах колоний микроорганизмов.
Монитор 55-Plus
Область применения: тестирование напитков и других жидкостей; поставляются стерильными; однократного применения; после фильтрации диск пропитывают 2 мл питательной среды и помещают в чашку Петри для инкубации.
Материал воронки, крышки и основания — полистирол;материал мембраны — эфиры целлюлозы;материал подложки — целлюлоза;диаметр фильтра, мм — 55;площадь фильтрации, см2 — 21,1;размер пор, мкм — 0,45;цвет фильтра — белый или черный;разметка фильтра.
Питательные среды для мониторинга микробиологической контаминации жидкостей:
бульон триптиказный соевый — для диагностики наличия грибов и аэробных бактерий; возможно использование для приготовления жидкой среды для подращивания смывов (преэнричменты);тиогликолевая среда жидкая — для обнаружения анаэробных бактерий; возможно применение для аэробных бактерий;тиогликолевая среда жидкая с увеличенной прозрачностью — аналогична предыдущей, но позволяет проводить турбидиметрические исследования при слабом росте и низких оптических плотностях;среда для тестирования питьевой воды на колиформы;среда для тестирования сточных вод на фекальные колиформы;среда для тестирования напитков и питьевой воды на дрожжи и плесневые грибы;среда неселективная для тестирования воды и других жидкостей на содержание гетеротрофных бактерий.